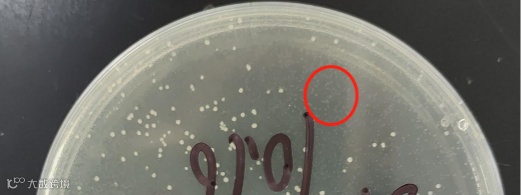

在合成生物学的实验室里,最令人沮丧的时刻之一,就是你满怀期待地走向培养箱,却发现本应长满菌落的平板上空空如也。这不是实验的偶然失败,而是一个设计精妙的“爆破”计划,在启动之前就提前泄露了。今天,我们要讲述的,就是一个关于噬菌体ΦX174中一个仅有276个碱基的微小基因——裂解基因E的故事。它不仅是一个高效的细菌杀手,更让我们领悟到,在生命系统的底层,一个“过于热心”的助手,是如何让整个工程计划濒临破产的。

一个小基因,何以100%致死?
噬菌体174E基因编码的蛋白是一种溶菌酶,具体来说是T4噬菌体溶菌酶。它的作用机制简单而粗暴:像一枚精确制导的炸弹,专门靶向细菌细胞壁的肽聚糖骨架,水解其中的β-1,4糖苷键。
作用靶点:细菌的细胞壁。
作用方式:该酶能够水解细胞壁肽聚糖中的β-1,4糖苷键。肽聚糖是维持细菌细胞形状和结构完整性的关键网络结构。
最终结果:一旦细胞壁被破坏,细菌细胞就无法抵抗内部的渗透压。在相对低渗的环境中,水会大量涌入细胞,导致细胞膨胀并最终裂解。这个过程就像拆掉了水坝的墙体,河水会瞬间冲垮结构一样。
因此,当174E基因在细菌细胞内成功表达并产生足够量的溶菌酶时,细胞裂解是不可避免的,致死率因此是100%。
这正是我们最初想利用它的原因: 在需要快速释放胞内蛋白时,或在特定条件下清除含有某种质粒的细菌时,基因E堪称一把理想的手术刀。
为何“完美杀手”却无法被“收编”?
然而,当科学家们尝试将这把“手术刀”的蓝图——基因E,克隆到质粒上,并转入大肠杆菌中进行保存和扩增时,却遭遇了彻底的失败。
在常规的实验菌株中,克隆的成功率极低,仅有0.4%。平板上几乎看不到菌落。而那些极少数的“幸存者”,经测序验证,其质粒上的基因E往往已经发生了突变,失去了功能。
我们从实验结果来看:在质粒还未来得及稳定复制和传代之前,宿主菌就因为174E基因的微量表达而被裂解,导致克隆失败。在平板上看不到菌落,或者只有极少数逃逸的菌落。
我们明明还没有诱导它表达,为什么细菌还是大批量地死亡?难道这把“手术刀”在刀鞘里就能杀人吗?
小菌落和逃逸的菌落(大菌落)
机制解析:YES复合物与SlyD的关键作用
传统观点难以解释为什么在无诱导条件下细胞仍会裂解。近年来的结构生物学研究揭示了其核心机制:YES三元复合物的形成。
宿主蛋白MraY:宿主细胞的膜结合酶,细胞壁合成的关键节点。
噬菌体蛋白E:噬菌体编码的裂解效应因子。
SlyD:宿主编码的FKBP类肽酰-脯氨酰顺反异构酶,兼具分子伴侣活性。
SlyD是裂解机制的“必要共犯”:在噬菌体的自然感染中,SlyD并不是一个需要被绕开的障碍,反而是蛋白E高效行使功能所必需的“分子伴侣”。它通过其伴侣结构域稳定地与蛋白E结合,帮助其精准地定位并抑制MraY的活性,从而高效地阻断细胞壁合成,引发裂解。
人工构建中的“背叛”:
自然感染:噬菌体在准备好“破壁而出”时,才在特定时机表达蛋白E,并立即利用宿主中已有的SlyD来快速形成YES复合物,完成裂解。
人工合成:当我们把基因E克隆到质粒上时,在构建过程中,细菌持续地、组成型地表达SlyD(SlyD蛋白在细菌的整个生命周期中持续不断地被合成)。这意味着,哪怕只有极微量的蛋白E被“泄露表达”(这是强启动子很难完全避免的),SlyD就会立刻上前“帮忙”,促使形成有功能的YES复合物,导致细胞提前裂解。
解决方案:创造一个“中立区”
真相大白后,解决方案变得清晰:既然无法阻止基因E的微量泄露,那就移除那个过于热心的“助手”。
先敲除SlyD,实质上是为裂解基因E的质粒构建创造一个“无菌、中立”的工作环境。在这个环境里,没有那个过于“热心”且能力强大的助手,基因E可以安全地被组装、复制和存储。而当我们真正需要它发挥作用时(例如,将质粒转入正常的、含有SlyD的致病菌中,或在进行诱导表达时),它就能完美地执行其裂解使命。
使用敲除菌,敲除菌成功率100%
使用常规菌,常规菌成功率0.4%
从困局到工具,广阔的应用场景
理解了这一机制后,基因E不再是一个难以驾驭的麻烦,而是变成了一个极具价值的精密工具。

高效蛋白纯化
在工业酶或生物制药蛋白的生产中,将目标蛋白与基因E置于同一诱导系统下。表达结束后,诱导基因E表达,可以瞬间裂解细胞,将胞内蛋白高效释放到发酵液中,极大简化下游纯化工艺,提高收率。

可控的质粒消除系统
在复杂的代谢工程或多质粒系统中,需要精确调控不同基因模块的存在。可以将基因E置于特定质粒上并施加严密调控。当需要将该质粒从群体中清除时,只需打开诱导开关,即可特异性杀死含有该质粒的细菌,实现“编程式”种群净化。

抗菌新策略的基础研究
基因E/SlyD系统为开发新型抗菌剂提供了思路。理论上,可以设计能够干扰MraY-SlyD相互作用的小分子,或构建靶向特定病原体的基因回路,实现精准的抗菌效果。
处理高毒性基因的经典范式
ΦX174基因E的克隆案例,超越了单纯的技术难题解决,它生动地阐释了合成生物学的一个核心理念:成功的外源系统重构,依赖于对宿主内在网络的深刻理解与工程化改造。
基因E的毒性并非孤立存在,而是通过与宿主因子SlyD形成功能性复合物得以实现。通过靶向这一宿主因子,我们成功地将一个难以驾驭的“杀手”基因,转化为一个可按需启用的高效生物工具。
泓迅生物
“合成+编辑”整合方案
泓迅生物专注于为客户提供一站式、定制化的基因合成与编辑解决方案,助力攻克类似的重磅研究难题。
精准基因编辑服务:凭借先进的基因编辑平台,我们可高效完成包括SlyD在内的各种基因敲除、点突变及 Knock-in,为您量身构建理想的工程菌株或细胞系,为复杂基因的克隆与功能研究扫清障碍。
高通量基因合成:无论您需要的是像ΦX174基因E这样具有挑战性的短基因,还是复杂的长片段,我们都能提供从序列优化、寡核苷酸合成到精准组装的全流程服务,确保100%的序列准确度。
“合成+编辑”整合方案:我们尤为擅长将基因合成与宿主工程相结合,为您提供从“基因蓝图”到“功能性底盘”的端到端服务,极大加速您的研发进程。






